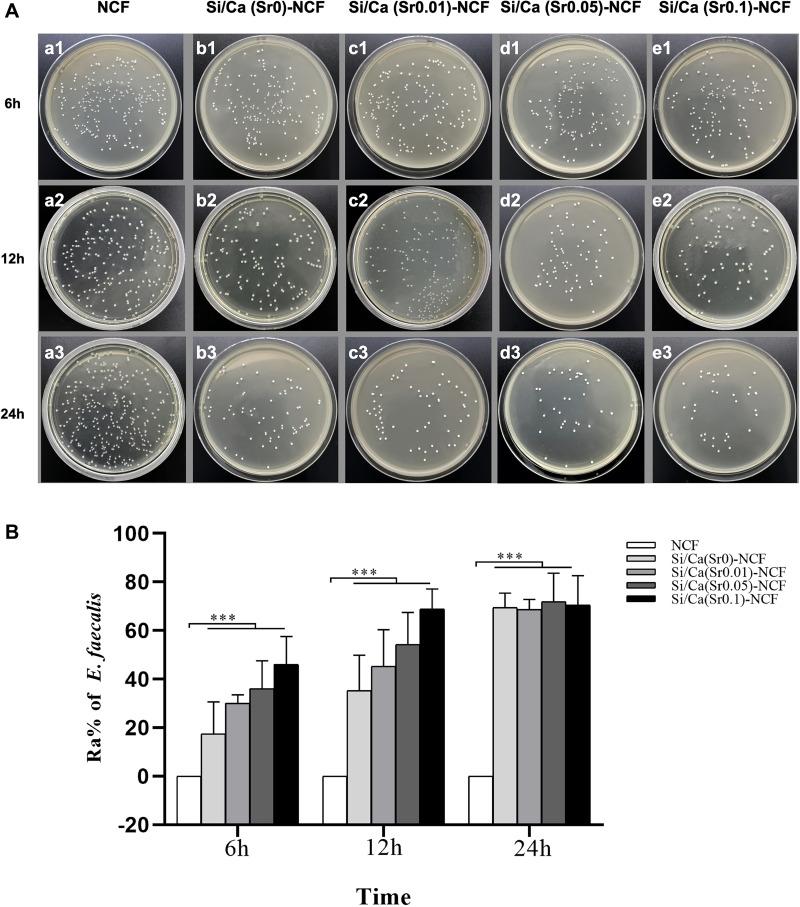
https://cdn.ncbi.nlm.nih.gov/pmc/blobs/098f/8710523/1ec8b389be3a/IJN-16-8251-g0006.jpg

利用无机硅稳定纳米颗粒分散的电子纺纳米纤维垫实现抗酸仿生牙本质再矿化。
Anti-Acid Biomimetic Dentine Remineralization Using Inorganic Silica Stabilized Nanoparticles Distributed Electronspun Nanofibrous Mats.
机构信息
Hospital of Stomatology, Guangdong Provincial Key Laboratory of Stomatology, Institute of Stomatological Research, Guanghua School of Stomatology, Sun Yat-sen University, Guangzhou, People's Republic of China.
The State Key Laboratory Breeding Base of Basic Science of Stomatology (Hubei - MOST) & Key Laboratory of Oral Biomedicine Ministry of Education, School & Hospital of Stomatology, Wuhan University, Wuhan, People's Republic of China.
出版信息
Int J Nanomedicine. 2021 Dec 21;16:8251-8264. doi: 10.2147/IJN.S331321. eCollection 2021.
BACKGROUND
To manage the sharp pain of dentine hypersensitivity, various materials are utilized to conduct dentine remineralization. However, many prior materials are limited with their single function and complicated operations. In this study, silica and calcium (strontium) carbonates mineralized nano cellulose fibrous (Si/Ca(Sr)-NCF) mat with the ability to release acid resistant and biomimetic mineralizational silica/calcium (strontium) carbonate co-precipitation nanoparticles (Si/Ca(Sr) NPs) were fabricated. The dentine occluding effects, antibacterial activity and cytocompatibility of the Si/Ca(Sr)-NCF mats were evaluated.
METHODS
The Si/Ca(Sr)-NCF mats were fabricated by dipping the electrospun nano cellulose fiber (NCF) into silica and calcium (strontium) carbonate liquid. Physicochemical characterizations and ion release were confirmed by scanning electron microscopy (SEM), Fourier transform infrared spectroscopy (FTIR), ion release assays and transmission electron microscopy (TEM). Sixty dentine discs were randomly divided into five groups: 1, blank NCF; 2, Si/Ca(Sr 0)-NCF; 3, Si/Ca(Sr 0.01)-NCF; 4, Si/Ca(Sr 0.05)-NCF; 5, Si/Ca(Sr 0.1)-NCF. Dentine discs were mineralized by the mats and observed with SEM immediately, after acid challenge and remineralized in artificial saliva. The releasing liquid was investigated by TEM and type I collagen model. Then, antibacterial property and cytocompatibility were evaluated.
RESULTS
SEM and TEM results confirmed that the experiment mats continuously released amorphous Si/Ca(Sr) NPs and consequently realized anti-acid dentine biomimetic remineralization. Homogeneous surface coverage and collagen intrafibrillar mineralization in strontium adding groups illustrated the mineralization effect was not only by in site precipitation, but also collagen heterogeneous nucleation. Additionally, acceptable antibacterial and cytocompatibility properties were illustrated in low and middle Sr containing mats.
CONCLUSION
In vitro studies on human dentine discs and type I collagen demonstrated that Si/Ca(Sr)-NCF system was a multifunction system inducing anti-acid, biomimetic, antibacterial and cytocompatible dentine remineralization. This multifunction mat would be a promising DH treatment candidate for complicated exposed dentine surfaces.
背景
为了治疗牙本质敏感症的剧烈疼痛,各种材料被用于进行牙本质再矿化。然而,许多先前的材料由于其单一功能和复杂的操作而受到限制。在本研究中,制备了具有抗酸和仿生矿化硅酸/碳酸钙共沉淀纳米颗粒(Si/Ca(Sr) NPs)释放能力的硅/钙(锶)碳酸盐水化纳米纤维素纤维(Si/Ca(Sr)-NCF)垫。评估了 Si/Ca(Sr)-NCF 垫的牙本质封闭效果、抗菌活性和细胞相容性。
方法
通过将电纺纳米纤维素纤维(NCF)浸入硅和钙(锶)碳酸盐溶液中来制备 Si/Ca(Sr)-NCF 垫。通过扫描电子显微镜(SEM)、傅里叶变换红外光谱(FTIR)、离子释放测定和透射电子显微镜(TEM)确认物理化学特性和离子释放。将 60 个牙本质圆盘随机分为五组:1. 空白 NCF;2. Si/Ca(Sr0)-NCF;3. Si/Ca(Sr0.01)-NCF;4. Si/Ca(Sr0.05)-NCF;5. Si/Ca(Sr0.1)-NCF。用垫矿化牙本质圆盘,并立即在酸挑战后和在人工唾液中再矿化后用 SEM 观察。通过 TEM 和 I 型胶原模型研究释放液。然后,评估抗菌性能和细胞相容性。
结果
SEM 和 TEM 结果证实,实验垫持续释放无定形 Si/Ca(Sr)NPs,从而实现抗酸牙本质仿生再矿化。锶添加组中均匀的表面覆盖和胶原原纤维内矿化表明,矿化效果不仅是原位沉淀,而且是胶原异质成核。此外,在低浓度和中浓度含 Sr 的垫中表现出可接受的抗菌和细胞相容性。
结论
在人牙本质圆盘和 I 型胶原上的体外研究表明,Si/Ca(Sr)-NCF 系统是一种诱导抗酸、仿生、抗菌和相容的牙本质再矿化的多功能系统。这种多功能垫将成为治疗复杂暴露牙本质表面的 DH 的有前途的候选物。